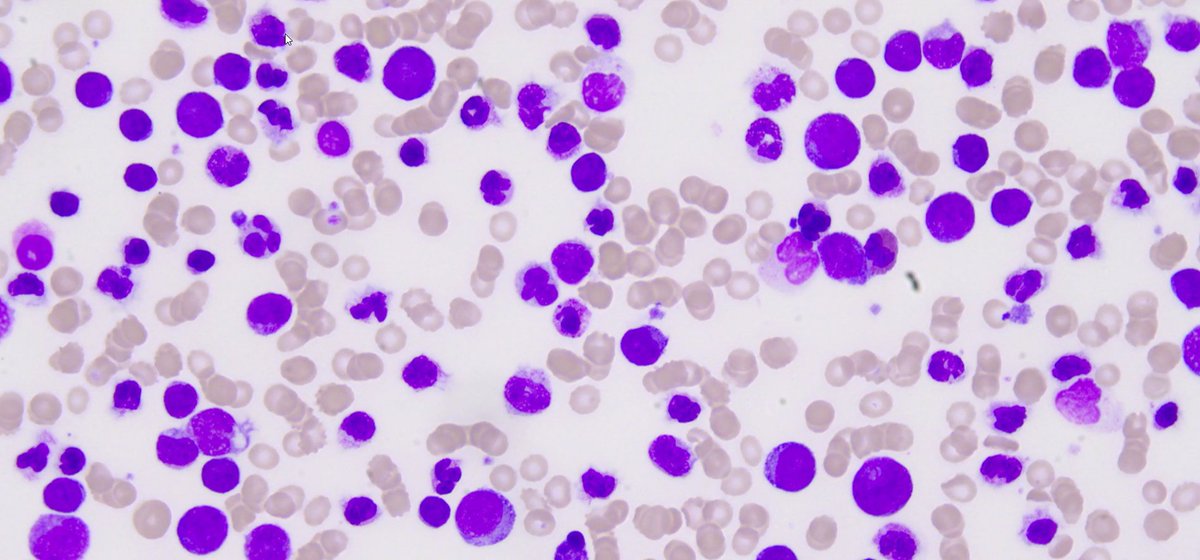
Ding tweet media

Sabitlenmiş Tweet
Ding
752 posts



@ruud_stoof Wooooow mayo! That's sounds perfect 🥰👍 *writing it down ✍️✍️✍️✍️
English

@Dingdingading Awesome Ding! It’s certainly got my approval! Needs a bit of mayonnaise. open.spotify.com/track/7tzgX2LH…
English

@mona8schmona I read that serum is mostly protein so the texture is very similar to egg white 😃
English

@Dingdingading Wow! It makes sense in concept but is still amazing to see the result of an "experiment." How is the texture? First time I had a porcine blood pudding, I was taken aback by the way it rubbed under my teeth, and I still wonder if that was due to RBC / PLT / clotting factors.
English

@Dingdingading 😂 Where has that magnet been before? Did you clean it well?
English

@camillalnord I made a right choice to check out twitter before submitting....
English